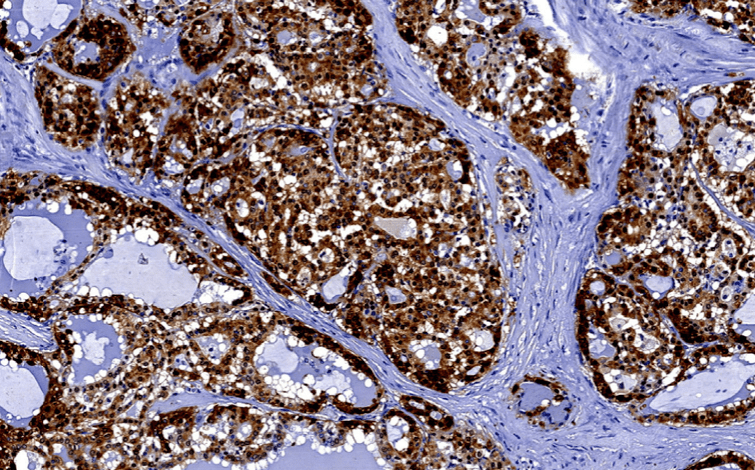

- Mammary analog secretory carcinoma (MASC):
- Is a recently described salivary gland tumor:
- That was likely classified as acinic cell carcinoma in the past
- Is a recently described salivary gland tumor:
- The tumor has striking histologic and molecular similarities:
- To secretory carcinoma of the breast
- Secretory carcinoma of the breast (SC):
- Has shown to have a recurrent balanced chromosomal translocation:
- t(12;15) (p13;q25):
- Which leads to an oncogenic fusion gene ETV6-NTRK3
- t(12;15) (p13;q25):
- This translocation is also present in MASC:
- This fusion gene encodes a chimeric tyrosine kinase:
- That is known to play an important role on its oncogenesis
- This fusion gene encodes a chimeric tyrosine kinase:
- Has shown to have a recurrent balanced chromosomal translocation:
- Immunohistochemical similarities between MASC and SC of the breast also include:
- Being S100 protein, epithelial membrane antigen (EMA), and vimentin positive and “triple negative” (ER/PR/Her2 negative)
- MASC predominantly affects:
- Men and normally does not behave in an aggressive biology
- The parotid gland is the most common affected gland by MASC
- The official terminology of this entity:
- Is now “secretory carcinoma”
- At the histologic level:
- Tumor cells have eosinophilic or clear bubbly cytoplasm:
- They may grow as tubules or microcysts, papillae, or macrocysts
- Secretions are almost always present:
- In the microcysts and / or macrocysts
- Tumor cells have eosinophilic or clear bubbly cytoplasm:
- MASC characteristically harbors:
- A balanced chromosomal translocation (12, 15):
- Resulting in the formation of the ETV6–NTRK3 fusion genes
- A balanced chromosomal translocation (12, 15):
- Even though they have similar growth rate between MASC and ACC:
- MASC is more likely to metastasize to the regional lymph nodes:
- It should be considered as a more aggressive tumor compared with the regular low grade ACC
- MASC is more likely to metastasize to the regional lymph nodes:
- MASC usually presents as a painless:
- It is a non-tender mass that increases in size overtime
- The majority of MASC arise from the parotid gland;
- Accounting for two thirds of the reported cases
- The mean age for presentation of MASC is 47 years:
- In contrast with SC of the breast that usually occurs in younger patients
- MASC:
- Is considered a low-grade carcinoma with a favorable prognosis:
- According to Skálová et al:
- It has moderate risk for local recurrence (15%)
- Lymph node metastases (20%)
- Low risk for distant metastases (5%)
- According to Skálová et al:
- Is considered a low-grade carcinoma with a favorable prognosis:

#Arrangoiz #CancerSurgeon #HeadandNeckSurgeon #SurgicalOncologist #MASC #MammaryAnalogSecretoryCarcinoma #SalivaryGlandTumors #MSMC #MountSinaiMedicaCenter #Mexico #Miami
